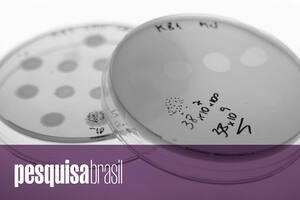

Podcast Pesquisa Brasil
Podcast

O Brasil das montanhas
Podcast expõe um debate científico sobre a classificação do relevo do país. E mais: reprogramação de células; competitividade; ecossistemas aquáticos
Por Pesquisa Brasil
Podcast

O redesenho dos povos originários
Podcast discute os fatores que levaram ao crescimento de 89% da população autodeclarada indígena no país entre 2010 e 2022. E mais: idosos; pós-graduação; neurônios
Por Pesquisa Brasil
PODCAST

Artilharia contra fake news
Podcast discute o alcance de ferramentas computacionais criadas no país para rastrear e combater a desinformação. E mais: gotículas; endoscopia; xenotransplantes
Por Pesquisa Brasil
PODCAST

Inovação na mesa de bar
Podcast mostra o esforço de pesquisadores para criar cervejas usando leveduras da biodiversidade brasileira. E mais: cicatrização; bolsas científicas; papel
Por Pesquisa Brasil
PODCAST

Risco no fundo do copo
Podcast discute novas estratégias para enfrentar o consumo abusivo de álcool e drogas. E mais: vida longa; ferramentas genéticas; vírus endêmico
Por Pesquisa Brasil
Podcast

Formação médica sob julgamento
Podcast discute como faculdades de medicina sem qualidade maculam o esforço para ampliar a oferta de profissionais no país. E mais: agtechs; competição; neurônios
Por Pesquisa Brasil
PODCAST

A propagação dos bioplásticos
Podcast aborda o desenvolvimento de polímeros à base de madeira, mandioca, açaí e resíduos agrícolas em universidades e empresas brasileiras. E mais: curiosidade científica; agências de fomento; biomarcadores
Por Pesquisa Brasil
PODCAST

Escolaridade tardia
Podcast discute as razões da queda nas matrículas da Educação de Jovens e Adultos no país. E mais: frutos, fertilizantes, humilhações
Por Pesquisa Brasil
PODCAST

O medo desafiado
Podcast debate a reavaliação dos riscos da reposição hormonal na menopausa. E mais: picadas; esportes; tetrápode
Por Pesquisa Brasil
Podcast

Para a receita não desandar
Podcast aborda o esforço de pesquisadores para controlar a qualidade do cacau e do chocolate produzidos no Brasil. E mais: função pulmonar, campos rupestres, rotas migratórias
Por Pesquisa Brasil
Podcast
Vírus que destroem bactérias
Podcast discute o potencial da fagoterapia, tratamento capaz de combater infecções resistentes a antibióticos. E mais: masculinidade; moringa; mobilidade
Por Pesquisa Brasil
Podcast

Cuidar sob pressão
Podcast discute as transformações no mercado de trabalho e no perfil dos enfermeiros do Brasil. E mais: variantes genéticas; felino em perigo; filmes comestíveis
Por Redação
PODCAST

Impactos do clima mais quente e seco
Podcast discute como o fogo tem efeitos distintos no Cerrado e no Pantanal. E mais: hormônio do bem-estar; poluição marinha; letras populares
Por Pesquisa Brasil
PODCAST

O marco regulatório da cannabis medicinal
Podcast discute como as normas da Anvisa terão impacto no cultivo e produção da planta para fins de pesquisa. E mais: gordura marrom; branqueamento de corais; créditos de carbono
Por Pesquisa Brasil
PODCAST

Bioinsumos versus agrotóxicos
Podcast discute o avanço dos inseticidas e fertilizantes biológicos na agricultura brasileira. E mais: mamíferos; saúde mental; ação antimicrobiana
Por Pesquisa Brasil
podcast

Perspectivas dos povos originários
Podcast discute como museus brasileiros estão criando formas novas de curadoria de arte indígena. E mais: contaminação; cetáceos; picadas
Por Pesquisa Brasil
Podcast

Proteção contra o câncer cervical
Podcast analisa as primeiras evidências de que a vacinação contra o HPV está reduzindo a incidência de tumores de colo do útero no Brasil. E mais: apito; jumentos; astrobiologia
Por Pesquisa Brasil
PODCAST

O gênero na moradia popular
Podcast discute o lugar que a arquitetura moderna reservou para as mulheres em projetos de conjuntos habitacionais. E mais: regurgito; acervo digitalizado; periquito-da-praia
Por Pesquisa Brasil
PODCAST

Ambientes de inovação
Podcast analisa os avanços e as limitações dos parques tecnológicos brasileiros em sua missão de conectar empresas e universidades. E mais: segurança alimentar; fotoeletrolisador; análise estatística
Por Pesquisa Brasil
Podcast

Cenas do próximo capítulo
Podcast aborda o lançamento do novo padrão tecnológico da TV aberta brasileira, que agrega recursos de streaming. E mais: formação de médicos; atividade física; solo contaminado
Por Pesquisa Brasil
PODCAST

Territórios agrícolas em movimento
Podcast discute como culturas vêm migrando para novas áreas no Brasil e como as mudanças climáticas podem acelerar esse processo. E mais: biorrepositório; peixe-jaguar; simbiose
Por Pesquisa Brasil
PODCAST

Viagem de ida e volta
Podcast discute como o turismo causa impacto no meio ambiente e também sofre com os efeitos das mudanças climáticas. E mais: ortorexia nervosa; acarofauna brasileira; sintomas persistentes
Por Pesquisa Brasil
PODCAST

Reforços contra a dengue
Podcast discute o alcance de novas estratégias para enfrentar a doença: uma vacina de dose única e uma fábrica de mosquitos que não espalham o vírus. E mais: ciência chinesa; robôs submersíveis; flores tropicais
Por Pesquisa Brasil
PODCAST

A propagação da violência
Podcast discute as razões do aumento da criminalidade na Amazônia legal e em cidades médias do país. E mais: cetáceos; bem-estar; Brasil Colônia
Por Pesquisa Brasil
Podcast

O repertório cultural dos animais
Podcast aborda a diversidade de comportamentos que certas espécies aprendem e transmitem socialmente e discute a importância de conservá-la. E mais: produção científica; gestão de árvores; impacto emocional
Por Pesquisa Brasil
Podcast

A multiplicação do etanol
Podcast discute como matérias-primas além da cana-de-açúcar estão diversificando a produção do biocombustível brasileiro. E mais: vídeos premiados; biossegurança; vassoura-de-bruxa
Por Pesquisa Brasil
PODCAST

Indicadores mais abrangentes
Podcast discute iniciativas para aumentar a oferta e a qualidade de dados sobre ciência, tecnologia e inovação do país. E mais: soja, cérebro, modelagem
Por Pesquisa Brasil
PODCAST

Fronteiras da cartografia
Podcast discute como comunidades tradicionais e de periferias estão usando mapas para dar visibilidade a seus territórios. E mais: saúde mental; phantoms; calor extremo
Por Pesquisa Brasil
PODCAST

Novos olhares sobre a floresta
Podcast mostra como expedições científicas estão explorando lugares e temas de pesquisa pouco conhecidos da Amazônia. E mais: capacidade fiscal; totens nas praias; transtornos psiquiátricos
Por Pesquisa Brasil
